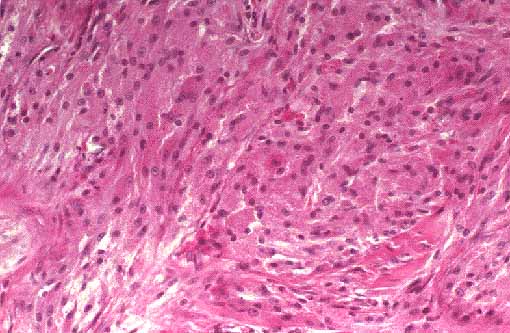
fig. 3

TUMOR MALIGNO DE CÉLULAS GRANULARES.
PELIGROS GÓMEZ, M.I., RICO MORALES M.L., PÉREZ RODRIGUEZ F.J., MONTENEGRO DÁMASO T, ÁLVAREZ FERNÁNDEZ E.

ICONOGRAFÍA
 |
|
Figura 1 |
 |
|
Figura 2 |
|
|
Figura 3 |
 |
|
Figura 4 |
 |
|
Figura 5 |
PELIGROS GÓMEZ, M.I., RICO MORALES M.L., PÉREZ RODRIGUEZ F.J., MONTENEGRO DÁMASO T, ÁLVAREZ FERNÁNDEZ E.
Copyright © 1998. Reservados todos los derechos.